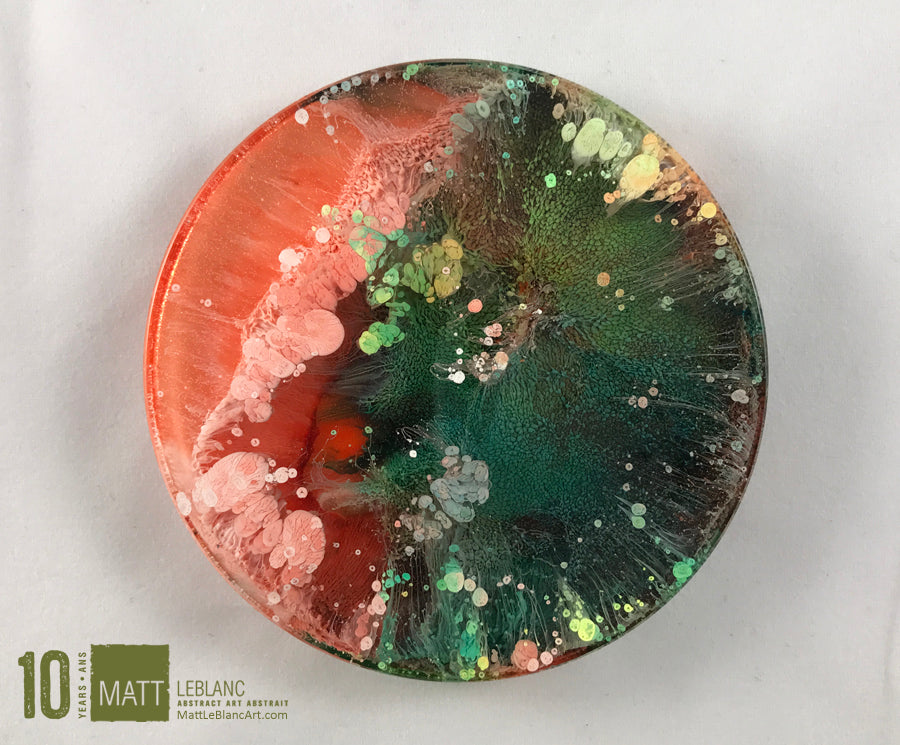
Matt LeBlanc Supernova Art - 3.5" round - 0036

Matt LeBlanc Art
Matt LeBlanc Supernova Art - 3.5" round - 0036
$0.00
This artwork was sold to a happy client but lets chat about designing your very own piece.
A custom order is available. Please send me an email so we can discuss size, style and colours. Custom orders are the same price as a regular artwork and you always get the option to buy it or not when it's done. It's a no stress no pressure approach of getting your own artwork done.